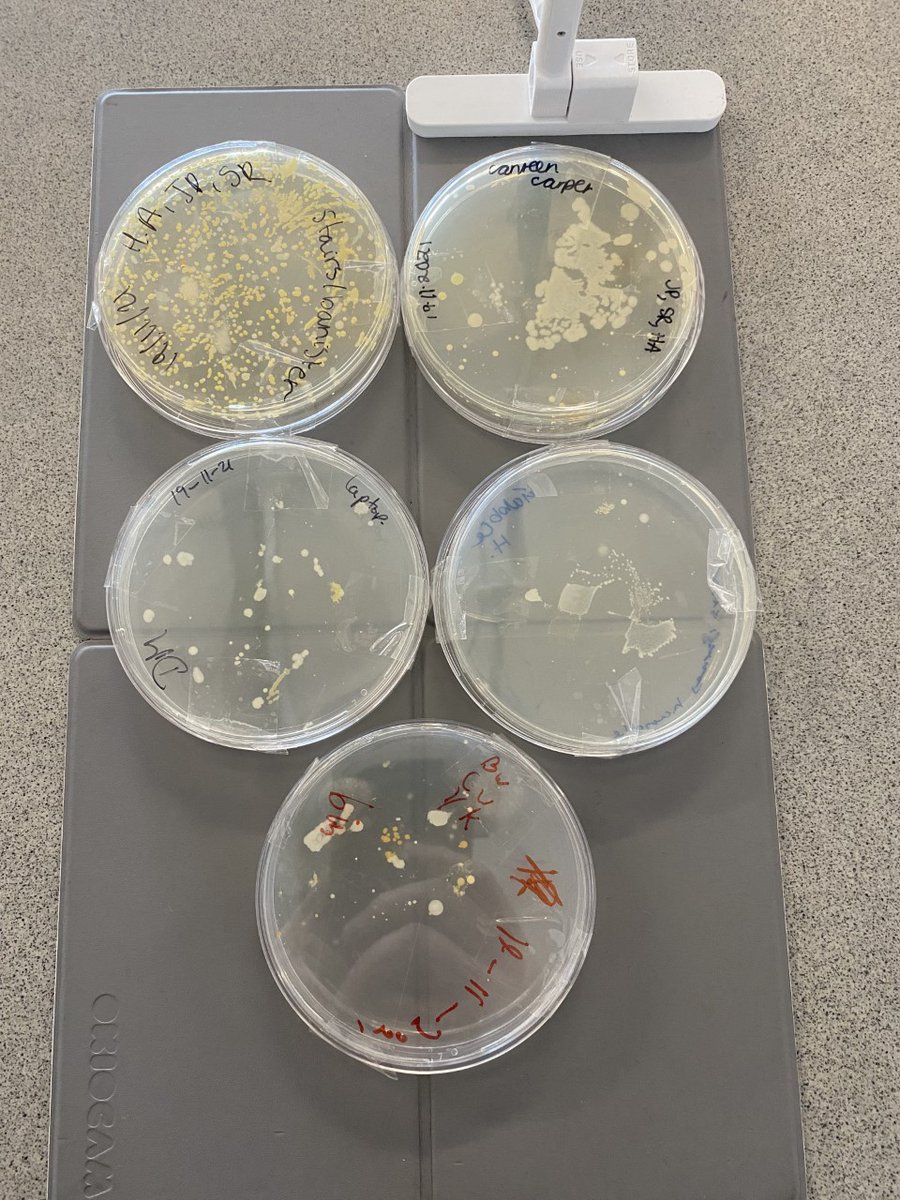
Look what has been growing over the weekend. The results of year 11's swop test from around our school site.

RPCC Science
@scirpcc
This is the Twitter account for the Regents Park Community College science department. We are an inner city Southampton school, with 7 science labs.
ID: 1336602047999856641
http://regentsparkcollege.org.uk 09-12-2020 09:23:17
77 Tweet
47 Followers
64 Following



Hey @speakrs4schools Robert Peston we've pulled a pack together for young people that showcases some of the best work ex. and volunteering ops around - and you're in it! Trying to get the resource out there so would love a RT if poss. Find the pack here: bit.ly/3AEEc3p


RPCC Science had a brilliant afternoon at Foundry Lane Primary School, yesterday. We lead the year 6 sessions on the heart, including some dissection! It's wonderful to meet amazing pupils and to help inspire future scientists 👩🔬👨🔬👩⚕️👨⚕️. We hope to be back again soon.Regents Park Community College




I would like to thank RSC BMCS for awarding Regents Park Community College RPCC Science their enhanced equipment grant. As you can see the students are impressed with our new heating mantles and distillation kits.


Calling all primary schools in Southampton. Regents Park Community College is creating a science equipment lending service. Please DM for further information. Southampton Co-operative Learning Trust Southampton schools






The brilliant Karen Collins gives #parents her best advice on the #ScienceGCSEs and how they can prepare themselves and their children for assessments in our latest blog post! tassomai.com/blog-content/2… @PiXLclub @PiXLScience


Osmosis required practical with Year 11 students earlier today, one of the many benefits to the science curriculum structure at Regents Park Community College is we can repeat the required practical multiple times. Make sure our students get a really good understanding.👨🔬👩🔬